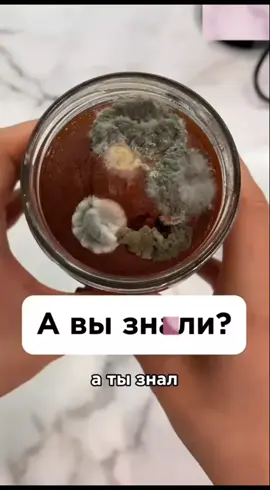

🦋MİLA👉🏼H🦋
Region: TR
Wednesday 15 October 2025 11:00:15 GMT
156
26
2
1
Music
Download
Comments
🚀İlkerTATAR34🚀 :
🙏🙏🙏
2025-10-15 11:01:59
1
Nihat can :
😂
2025-10-16 05:25:07
0
To see more videos from user @senisevmekten0, please go to the Tikwm
homepage.